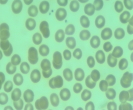
�l�ԃh�b�N ���t���� �̌�

人間ドック 血液検査項目と見方について

人間ドックに行ったとき、まず最初にされるのは、皆さんがイヤ〜な「採血」です。 でも、採血は人間ドックには絶対に欠かせない項目です。 なぜかというと、人の血液からは非常に多くの情報を得ることができるからですね
採血は「看護師さん」もしくは「臨床検査技師さん」が行なうことが多いのですが、やはり中には採血が下手な人もいるようで。。
私のように血管の細い場合や、気温が低い時期などは1回で血液を採れずに「何回も針を刺された」なんてこともあって、同じような方には採血がちょっとつらいものです。 また、新人さんにやってもらうとなるとちょっと心配です。 というか、これだけは悩みの種です。 腕を「パシパシ」叩かれたりして。。。

血液の話
ヒトの身体は恒常性といって、常にいつもと同じような正常な状態に保とうという機能が働いています。 血液の中の成分も同様に恒常性によって一定に保たれているのです。 しかも、誰でも正常な血液成分の構成に違いが少ない。つまり、誰でも血液の中身は同じようなものなのです。
それが「基準値」とか「正常値」といわれるものです。 「基準値」から外れていると、「何か異常があるのではないか? 」ということが疑われます。
例えば「GOT」。GOTというは肝臓の細胞に多く含まれている酵素です。 血液中のGOTの値が高くなっているということは、肝臓の細胞が通常より多く壊れていると考えられます。 そこで、肝臓の細胞が通常より多く壊れているのは「肝臓の炎症」などを疑うのです。 ただ、肝臓の炎症といっても原因は様々ですから、これは人間ドックの範疇ではなく、一般的に保険診療で「精密検査」をすることになります。 (健康保険組合によっては2次検査を負担してくれるところもあります)
人間ドックで実施される血液検査項目

一般的な人間ドックで実施されている血液検査 項目を挙げます。 もちろん受ける人間ドックやコースの内容によって、実施する検査項目数は多少上下するようですが、通常の人間ドックで検査ができる項目を挙げてみました。
血液検査
赤血球数(RBC)・ヘモグロビン(Hb)・ヘマトクリット(Ht)
赤血球指数
白血球数(WBC)
血小板数(PLT)
赤血球沈降速度(ERS) 他
電解質(ミネラル分)
カリウム(K)
ナトリウム(Na)
クロール(Cl)
カルシウム(Ca)
リン(P) 他
脂質検査
総コレステロール
LDLコレステロール
HDLコレステロール
中性脂肪(TG) 他
糖代謝検査
空腹時血糖
HbA1c(グリコヘモグロビン)
経口的糖負荷試験(OGTT) 他
血中蛋白質
総蛋白(TP)
アルブミン
A/G比 他
非蛋白性窒素
尿酸(UA)
尿素窒素
クレアチニン
クレアチン 他
肝機能検査
総ビリルビン
チモール混濁試験(TTT)
硫酸亜鉛混濁試験(ZTT)
GOT(AST)
GPT(ALT)
ALP
γ-GTP
コリンエステラーゼ
LAP
LDH 他
感染症検査
B型肝炎
C型肝炎
HIV
梅毒検査 他
その他
CRP
リウマチ因子(RF)
血液型 他
オプション検査
腫瘍マーカー
(CEA・AFP・CA19−9・PSA・CA125等)
人間ドックの血液検査項目と結果記事一覧
人間ドックの血液検査と結果について|赤血球数(RBC)
赤血球は酸素を体中の細胞に運ぶという大切な役目をしています。赤血球は骨髄の中でつくられて、約120日の役目を終えると肝臓や脾臓で壊され、様々な経路から体外に排泄されます。
人間ドックの血液検査と結果について|ヘモグロビン(Hb)
赤血球は酸素を体中の細胞に運ぶという大切な役目をしています。赤血球は骨髄の中でつくられて、約120日の役目を終えると肝臓や脾臓で壊され、様々な経路から体外に排泄されます。
人間ドックの血液検査と結果について|ヘマトクリット(Ht)
赤血球は酸素を体中の細胞に運ぶという大切な役目をしています。赤血球は骨髄の中でつくられて、約120日の役目を終えると肝臓や脾臓で壊され、様々な経路から体外に排泄されます。
人間ドックの血液検査と結果について|赤血球指数
赤血球は酸素を体中の細胞に運ぶという大切な役目をしています。赤血球は骨髄の中でつくられて、約120日の役目を終えると肝臓や脾臓で壊され、様々な経路から体外に排泄されます。赤血球指数赤血球指数とは、赤血球数やヘモグロビン(Hb)、ヘマトクリット(Ht)の値から算出した指数で、MCV(平均赤血球容積)・...
人間ドックの血液検査と結果について|白血球数(WBC)
白血球は細菌やウイルスといった感染症、そして自分の体にできた「がん細胞」を取り除くといった「免疫」を担う大切な役割があります。白血球と一口に言っても数種類の細胞があり、代表的なものは顆粒球といわれる「好中球・好酸球・好塩基球」と、顆粒のない「リンパ球・単球」などがあります。
人間ドックの血液検査と結果について|血小板数(PLT)
血小板は怪我をしたりして、血管に傷がついたときなどに出血を止める役割があります。 血小板がなかったら、人は出血によってすぐに命を落としてしまうといっても過言ではありません。それくらい大切な役割を果たしています。ただ、この出血を止めるという機能が「あだ」になり、血管を詰らせてしまうこともあります。 大...
人間ドックの血液検査と結果について|赤血球沈降速度(ERS)
赤血球は酸素を体中の細胞に運ぶという大切な役目をしています。赤血球は骨髄の中でつくられて、約120日の役目を終えると肝臓や脾臓で壊され、様々な経路から体外に排泄されます。
人間ドックの血液検査と結果について|電解質(Na・Cl・K)
血液中の電解質にはカリウム(K)やナトリウム(Na)、クロール(Cl)、カルシウム(Ca)、リン(P)、マグネシウム(Mg)などがあり、血液の中でイオンの状態で存在しています。 電解質は、人の細胞活動や血液中の水分・pHの維持、また神経の伝達や筋肉を動かすことなどに深く関わっています。
人間ドックの血液検査と結果について|コレステロール
コレステロールは、ヒトの身体の中で細胞膜に含まれたり、性ホルモンや、副腎皮質ホルモン等ステロイドホルモンの原料になったり、ビタミンD等身体を維持するためになくてはならない脂質成分です。コレステロールは、よく「悪者」扱いされますが、ヒトの身体には絶対に必要な成分です。コレステロールは食事からも摂取され...
人間ドックの血液検査と結果について|糖尿病の検査
血液検査「おしっこ」にアリが群がる!!古い昔、糖尿病の人の「おしっこ」に甘い糖分が混ざっていたことから付けられた病気の名前が「糖尿病」。 ところが、おしっこから糖分がでてくるのは病気がかなり進んでいたり、腎臓まで悪くなってきてからの話。 現在では、尿の中に糖分が含まれていなくても、血液中の濃度が一定...
人間ドックの血液検査と結果について|糖尿病の検査2
「おしっこ」にアリが群がる!!古い昔、糖尿病の人の「おしっこ」に甘い糖分が混ざっていたことから付けられた病気の名前が「糖尿病」。 ところが、おしっこから糖分がでてくるのは病気がかなり進んでいたり、腎臓まで悪くなってきてからの話。 現在では、尿の中に糖分が含まれていなくても、血液中の濃度が一定以上高い...
人間ドックの血液検査と結果について|糖尿病の検査3
糖尿病の精密検査人間ドックで「血糖値が高い」といわれても、すぐに糖尿病と診断されるわけではありません。 もっとちゃんと精密検査をして糖尿病かどうかを調べる必要があります。そこで出てくるのが「経口的糖負荷試験(OGTT)」です。 空腹時の血糖の値と経口的糖負荷試験(OGTT)の結果を組み合わせて糖尿病...
人間ドックの血液検査と結果について|TP(総蛋白)
人の体にはタンパク質が多く含まれているのは、みなさん御存知の通りです。食品における3大栄養素にも出てきますので、体に必要なものだってことも知っていますよね。筋肉や皮膚、髪の毛など、体のいたるところにタンパク質が存在していますが、もちろん血液中にも蛋白質が含まれています。血液中のタンパク質には、アルブ...
人間ドックの血液検査と結果について|尿酸(UA)
尿酸は体の中で不要になった細胞の核が分解されたり、摂取しすぎたプリン体の代謝でできたものです。尿酸が血液中に増えすぎると「痛風」という病気になることから、尿酸はよく知られている物質だと思います。
人間ドックの血液検査と結果について|尿素窒素(BUN)
尿素窒素? 何それ?? です ^^;そういえば、ハンドクリームに入ってるような。。。(あ、あれは尿素を分解する酵素 「ウレアーゼ」 だっけ!)体の中で不要になったタンパク質は、肝臓などでバラバラに分解されて、最終的に 「尿素」 として おしっこ の中から体外へ排泄されます。そうそう、タンパク質の特徴...
クレアチニン|人間ドックの血液検査と結果について
人間ドックでの血液検査で「クレアチン」「クレアチニン」という検査の項目があります。この2項目、「ニ」があるかないかの違いだけで、名前は似ているけど検査の意味が全然違うらしい。
クレアチン|人間ドックの血液検査と結果について
人間ドックでの血液検査で「クレアチン」「クレアチニン」という検査の項目があります。この2項目、「ニ」があるかないかの違いだけで、名前は似ているけど検査の意味が全然違うらしい。
人間ドックの血液検査と結果について|ビリルビン
肝機能検査は人間ドックで大切な検査の項目です。血液検査で一般的に用いられる肝機能検査には「GOT」・「GPT」・「γ-GTP」・「ビリルビン」・「ALP」・「LDH」・「TTT」・「ZTT」などがあります。
人間ドックの血液検査と結果について|AST/ALT
血液検査肝機能検査は人間ドックで大切な検査の項目です。血液検査で一般的に用いられる肝機能検査には「GOT」・「GPT」・「γ-GTP」・「ビリルビン」・「ALP」・「LDH」・「TTT」・「ZTT」などがあります。
人間ドックの血液検査と結果について|ALP
肝機能検査は人間ドックで大切な検査の項目です。血液検査で一般的に用いられる肝機能検査には「GOT」・「GPT」・「γ-GTP」・「ビリルビン」・「ALP」・「LDH」・「TTT」・「ZTT」などがあります。
人間ドックの血液検査と結果について|γ-GTP
血液検査肝機能検査は人間ドックで大切な検査の項目です。血液検査で一般的に用いられる肝機能検査には「GOT」・「GPT」・「γ-GTP」・「ビリルビン」・「ALP」・「LDH」・「TTT」・「ZTT」などがあります。
人間ドックの血液検査と結果について|コリンエステラーゼ:ch-E
肝機能検査は人間ドックで大切な検査の項目です。血液検査で一般的に用いられる肝機能検査には「GOT」・「GPT」・「γ-GTP」・「ビリルビン」・「ALP」・「LDH」・「TTT」・「ZTT」・「コリンエステラーゼ:ch-E」などがあります。
人間ドックの血液検査と結果について|HBV検査
ウイルス性肝炎にはさまざまな種類があり、現在A型〜G型までの7種類が報告されています。その他にも多種多様なウイルスによって肝炎が引き起こされますが、普通はウイルス性肝炎といえば、A型〜G型の7種類を指すことが多いようです。B型肝炎は治療によって治癒するケースが多いのですが、中には慢性化して感染源(キ...
人間ドックの血液検査と結果について|HCV検査
ウイルス性肝炎にはさまざまな種類があり、現在A型〜G型までの7種類が報告されています。その他にも多種多様なウイルスによって肝炎が引き起こされますが、専らウイルス性肝炎といえば、この7種類を指すことが多いようです。ウイルス性肝炎の中でもC型肝炎は日本で約200万人が感染しているといわれ、免疫によって自...
人間ドックの血液検査と結果について|腫瘍マーカー
腫瘍マーカーとは?人間ドックの主な目的の一つに「癌(がん)を早期発見する」ということがあげられます。 よく人間ドックの血液検査で癌(ガン)がわかるといわれますが、これは腫瘍マーカーと呼ばれるものです。それでは腫瘍マーカーにはどのような種類があって、どんなガンがみつけられるのでしょうか? そして、すべ...
人間ドックの予約はネットで簡単!リクルートの運営する「ここカラダ」が便利です ^^
人間ドックの予約はネットで簡単!リクルートの運営する「ここカラダ」が便利です ^^
Pontaポイントもたまってお得!!